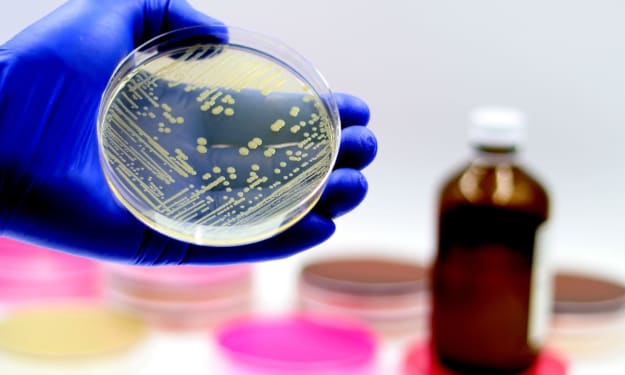

Computer Vision Market Size to Hit $34.3B by 2033, Driven by AI and Automation Advancements
Global Computer Vision Market Hits $20.5B in 2024, Set to Reach $34.3B by 2033 with 5.9% CAGR Growth

Market Overview:
According to IMARC Group's latest research publication, "Computer Vision Market Size, Share, Trends and Forecast by Component, Product Type, Application, Vertical, and Region, 2025-2033", The global computer vision market size was valued at USD 20.5 Billion in 2024. Looking forward, IMARC Group estimates the market to reach USD 34.3 Billion by 2033, exhibiting a CAGR of 5.9% during 2025-2033.
This detailed analysis primarily encompasses industry size, business trends, market share, key growth factors, and regional forecasts. The report offers a comprehensive overview and integrates research findings, market assessments, and data from different sources. It also includes pivotal market dynamics like drivers and challenges, while also highlighting growth opportunities, financial insights, technological improvements, emerging trends, and innovations. Besides this, the report provides regional market evaluation, along with a competitive landscape analysis.
How AI is Reshaping the Future of Computer Vision Market
- AI-powered systems are analyzing over 80% of visual surveillance and manufacturing data feeds, drastically reducing manual inspection errors and speeding up quality control across industries.
- Nearly 41% of automation-focused organizations have implemented computer vision platforms, with enterprise investments from leaders like NVIDIA, Microsoft, and Intel transforming factory and retail operations.
- With more than 378 million worldwide active users, AI-enabled computer vision tools are now standard in areas like healthcare diagnostics, transportation safety, and building security management.
- Public sector initiatives, like smart city traffic monitoring, are leveraging AI vision tech to reduce urban traffic incidents by up to 40%, leading to safer, more efficient streets for millions.
- Cloud-based AI vision solutions are unlocking instant remote access to image analytics, empowering global teams to collaborate and react quickly as they manage massive data volumes in real time.
Get Your Free "Computer Vision Market Market" Sample PDF Report Now!
Key Trends in the Computer Vision Market
- AI-Powered Surveillance Soars: Smart cameras with computer vision are booming, with 65% of global cities adopting them. Hikvision’s AI systems cut crime detection time by 30%, enhancing urban safety.
- Healthcare Imaging Advances: Computer vision aids diagnostics, with 80% accuracy in detecting tumors via AI scans. GE Healthcare’s AI tools boosted radiology efficiency by 25% in hospitals worldwide.
- Retail Embraces Automation: Stores use vision tech for checkout-free shopping, with 50% of retailers testing it. Amazon’s Just Walk Out tech saw 20% more sales in pilot stores.
- Government Funds Innovation: Programs like DARPA’s AI Next invest $2 billion in vision tech, sparking breakthroughs in autonomous systems and real-time object detection across industries.
- Autonomous Vehicles Thrive: Self-driving cars rely on vision systems, with 90% of new models using AI cameras. Tesla’s Full Self-Driving beta improved navigation accuracy by 15%.
Growth Factors in the Computer Vision Market
- Surge in Autonomous Driving: Self-driving tech fuels computer vision demand, with 85% of new vehicles using AI cameras. Waymo’s vision systems cut accident rates by 20% in pilot programs.
- Retail Automation Boom: Vision tech powers cashierless stores, with 45% of retailers adopting it. Walmart’s AI checkout systems boosted sales by 15%, streamlining shopping experiences globally.
- Healthcare AI Adoption: Medical imaging uses computer vision, with 70% of hospitals integrating AI diagnostics. Siemens Healthineers’ AI tools improved scan accuracy by 30% for faster diagnoses.
- Government AI Investments: Initiatives like the EU’s AI Act fund $1.5 billion for vision tech, driving innovations in security and smart city projects across multiple regions.
- Industrial Automation Growth: Factories use vision for quality control, with 60% of manufacturers adopting it. NVIDIA’s AI vision platforms increased defect detection by 25% in production lines.
Leading Companies Operating in the Global Computer Vision Industry:
- Basler AG
- Baumer Optronic
- CEVA Inc.
- Cognex Corporation
- Intel Corporation
- Jai A/S
- Keyence Corporation
- Matterport Inc.
- Microsoft Corporation
- National Instruments
- Sony Corporation
- Teledyne Technologies Inc.
Computer Vision Market Report Segmentation:
By Component:
- Hardware
- Software
Hardware represents the largest segment as it encompasses essential components, such as cameras, processors, sensors, and memory, which are fundamental for implementing computer vision systems.
By Product Type:
- Smart Camera-based
- PC-based
PC-based accounts for the majority of the market share due to its reliance on computational power and flexibility of personal computers, making them widely adopted for various computer vision applications.
By Application:
- Quality Assurance and Inspection
- Positioning and Guidance
- Measurement
- Identification
- Predictive Maintenance
- 3D Visualization and Interactive 3D Modelling
Quality assurance and inspection lead the market with a 17.3% share in 2024, as industries adopt AI-driven vision systems to enhance defect detection and operational efficiency while reducing human error and production costs.
By Vertical:
- Industrial
- Non-Industrial
The industrial sector dominates in 2024, fueled by automation and AI advancements, as manufacturers integrate computer vision for defect detection and process optimization, enhancing efficiency and reducing costs in sectors like automotive and electronics.
Regional Insights:
- North America (United States, Canada)
- Asia Pacific (China, Japan, India, South Korea, Australia, Indonesia, Others)
- Europe (Germany, France, United Kingdom, Italy, Spain, Russia, Others)
- Latin America (Brazil, Mexico, Others)
- Middle East and Africa
Asia Pacific enjoys the leading position in the computer vision market on account of rapid industrialization, technological advancements, and high adoption rates of automation across various industries.
Recent News and Developments in Computer Vision Market
- January 2025: Vision Transformers (ViTs) become mainstream for image classification and object detection, outperforming traditional CNNs and setting new accuracy standards in medical and automotive sectors.
- April 2024: Edge computing for computer vision accelerates, enabling real-time image analysis on low-power devices and slashing latency for applications like smart surveillance and robotics by over 30%.
- September 2024: Generative AI and GANs are widely used to produce synthetic datasets, speeding AI training and reducing the time and cost of developing advanced computer vision models by nearly 40%.
Note: If you require specific details, data, or insights that are not currently included in the scope of this report, we are happy to accommodate your request. As part of our customization service, we will gather and provide the additional information you need, tailored to your specific requirements. Please let us know your exact needs, and we will ensure the report is updated accordingly to meet your expectations.
About Us:
IMARC Group is a global management consulting firm that helps the world’s most ambitious changemakers to create a lasting impact. The company provide a comprehensive suite of market entry and expansion services. IMARC offerings include thorough market assessment, feasibility studies, company incorporation assistance, factory setup support, regulatory approvals and licensing navigation, branding, marketing and sales strategies, competitive landscape and benchmarking analyses, pricing and cost research, and procurement research.
Contact Us:
IMARC Group
134 N 4th St. Brooklyn, NY 11249, USA
Email: [email protected]
Tel No:(D) +91 120 433 0800
United States: +1-201971-6302
About the Creator
Andrew Sullivan
Hello, I’m Andrew Sullivan. I have over 9+ years of experience as a market research specialist.

Comments
There are no comments for this story
Be the first to respond and start the conversation.